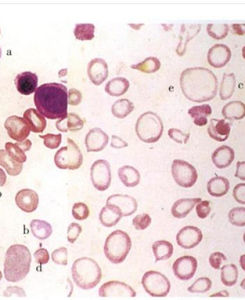

基本介紹

紅細胞
過肺泡同體外的氧氣進行氣體交換,將二氧化碳排出體外。血紅蛋白更易和一氧化碳相合,且血紅蛋白一旦與一氧化碳結合後就不易分離。當空氣中一氧化碳含量增高時且持續時間較長時,可引起一氧化碳中毒。
紅細胞的數量和血紅蛋白的含量減少到一定程度時,稱為貧血。紅細胞大量被破壞可引起溶血性黃疸。
紅細胞描述:哺乳動物的紅細胞呈兩面中央凹的圓餅狀,中央較薄。周緣較厚,故在血塗片標本上中央染色較淺、周圍較深。新鮮單個紅細胞為黃綠色,大量紅細胞使血液呈深紅色。成熟的紅細胞(哺乳動物)沒有細胞核和線粒體,富含血紅蛋白。依靠葡萄糖合成能量,平均直徑為7微米。光學顯微鏡下的紅細胞(未染色)
種類介紹
無脊椎動物的紅細胞
在無脊椎動物中具有紅細胞,只限于海生動物,如螠蟲、光裸星蟲、綠紐蟲、海豆芽、掃帚蟲、魁蛤、海棒槌等。涉及到各門約有100種,但也有的和白血球並沒有明顯區別,不過和脊椎動物的紅細胞則有明顯的差異。
脊椎動物的紅細胞
脊椎動物中哺乳類的紅細胞,是中心部凹陷的圓板狀,在造血組織中是有細胞核的,但在循環血中的紅細胞,除駱駝和羊駝之外,可看到細胞核退化,向細胞外放出、消失。紅細胞
鳥類以下的動物的紅細胞多數呈橢圓形,中心具核,中心部向兩面突出。
脊椎動物紅細胞的大小,可因動物種類不同而異,哺乳類的直徑為4—8微米(人的為6—9微米),厚度以1.5—2.5微米者為多見。鳥類的長徑為12—15微米,短徑為7—9微米,在爬行類的長徑為17—20微米,短徑為10—14微米,兩棲類的更大,長徑為23—60微米,短徑以13—35微米者較多。魚類的紅細胞的大小有明顯變異。
紅細胞數由於種的不同而異,但具有大形紅細胞的,一般在單位體積中血球減少。處於冬眠期的動物,比活動期顯著減少。
人的紅細胞
人類的紅細胞是雙面凹的圓餅狀。邊緣較厚,而中間較薄,就好像是一個甜甜圈一樣,只是當中沒有一個洞而已。這種形狀可以最大限度的從周圍攝取氧氣。同時它還具有柔韌性,這使得它可以通過毛細血管,並釋放氧分子,直徑通常是6μm~8μm。
由於這種特別的形狀而且體積比較小,所以表面積對體積的比值較大,使氧氣以及二氧化碳能夠快速地紅細胞
滲透細胞內外。紅細胞的細胞膜含有特別的多糖類以及蛋白質,但是這種結構因人而異,這些結構是構成血型的基本要素。
 紅細胞
紅細胞成人體內大約有2~3×10的13次方個紅細胞(女性大約為4~5百萬/微升血液,男性為5~6百萬/微升血液)。女性比男性少的原因,是因為生理出血造成的現象。另外睪丸酮也具有刺激紅細胞生成激素製造紅細胞的功能。
在人的紅細胞內所含的血紅蛋白占血球總量的30%以上,是血液中最通常的一種血細胞,在乾重9%時,占94%,隨著氧分壓的變化與氧結合或游離,但它的解離曲線和純血紅素的溶液不同,在氧分壓低的
組織,紅細胞具有放出多量氧的能力。另外,在紅細胞內,存在有碳酸脫氫酶,在將二氧化碳轉化為碳酸氫根離子的可逆反應中起觸媒作用。因此紅細胞運送血液二氧化碳的能力很強。
在人及其他哺乳動物中,成熟的紅細胞是無核的。這意味著它們失去了DNA。紅細胞也沒有線粒體,它們通過糖酵解途徑(無氧呼吸)合成能量。成熟的哺乳類紅細胞是雙凹圓盤狀,如此可增加其表面積,使物質更容易通過其細胞膜。光學顯微鏡下的紅細胞(未染色)
輸送功能
功能介紹
紅細胞含有血紅素(hemoglobin),其具有緩衝的作用。血紅素十分活躍,它既能和氧結合在一起,也能紅細胞
和二氧化碳結合。因此,其主要工作為運輸氧和二氧化碳。紅細胞的功能是運輸氧,二氧化碳,電解質,葡萄糖以及胺基酸這些人體新陳代謝所必須的物質。此外還在酸鹼平衡中起一定的緩衝作用。這兩項功能都是通過紅細胞中的血紅蛋白來實現的。如果紅細胞破裂,血紅蛋白釋放出來,溶解於血漿中,即喪失上述功能。
紅細胞通過血紅蛋白運送氧氣,紅細胞的90%由血紅蛋白組成。血紅蛋白是一種紅細胞相關的化合物肌紅蛋白,在肌肉細胞中存儲氧氣。血紅蛋白(Hb)由珠蛋白和亞鐵血紅素結合而成。血液呈現紅色
紅細胞
紅細胞就是因為其中含有亞鐵血紅素的緣故。它可以在肺部或腮部臨時與氧氣分子結合,該分子中的Fe2+在氧分壓高時,與氧結合形成氧合血紅蛋白(HbO2);在氧分壓低時,又與氧解離,身體的組織中釋放出氧氣,成為還原血紅蛋白,由此實現運輸氧的功能。血紅蛋白也可以運送由機體產生的二氧化碳(不到氧氣總量的2%,更多的二氧化碳由血漿解決)。血紅蛋白中Fe2+如氧化成Fe3+,稱高鐵血紅蛋白,則喪失攜帶氧氣的能力。血紅蛋白與一氧化碳的親和力比氧的大210倍,在空氣中一氧化碳濃度增高時,血紅蛋白與一氧化碳結合,因而喪失運輸氧的能力,可危及生命,稱為一氧化碳中毒(即煤氣中毒)。
每個紅細胞含有兩億到二十億個血紅素分子,占了紅細胞重量的三分之一。每個血紅素分子由四個次體構成,每個次體包含一個血基質(heme)以及一個和血基質連線的多肽。血紅素內的多肽稱為球蛋白(globin),而每個血基質當中有一個鐵原子,此處可以和一個氧分子結合。因此,一個血紅素可以和四個氧分子結合。女性血紅素的平均濃度為14g/L,男性的血紅素平均濃度為16g/L。在體內,不是只有血紅素含有鐵原子,像細胞色素是另外一種含鐵原子的分子。
肺中的氧氣張力高,血紅素在微血管中與氧結合,形成充氧血紅素,充氧血紅素在氧氣張力較低的組織微血管中釋出氧氣。而二氧化碳是以碳酸、重碳酸離子以及鉀和鈉的重碳酸鹽的形式進行運輸。血紅素和氧結合時,血液就變得鮮紅,變成動脈血,和二氧化碳結合時,血液就變得暗紅,變成靜脈血。
血紅素既能和它們很快地結合,而且還能夠和它們分開。當紅細胞流經肺里的時候,它就跟氧結合在一起並把氧運送到人體全身的各個角落裡,讓肌肉、骨骼、神經等細胞得到氧氣,能夠正常地工作。紅細胞把氧氣送出後就很快地和氧氣分離,立刻帶走了這些細胞排出的二氧化碳,運回肺部呼出體外。
另外,並非所有的血紅素的構造都相同,例如胎兒的血紅素比成年人的血紅素有著更強的氧親和力,在任何氧分壓下,都有著比母親血紅素為高的百分比,因而能從母親的血液中獲取氧,胎兒出生後二十個星期,血紅素就變為成年人的形式了。
紅細胞就是這樣忠誠地把氧氣運輸給人身體組織的各部位,再從各部位運送出代謝產物二氧化碳,所以紅細胞是我們人體內不可缺少的“運輸隊”。
紅細胞中的血紅蛋白
成熟的紅細胞沒有細胞核,富含血紅蛋白。血紅蛋白是一種含鐵的蛋白質,呈紅色。它在氧含量高的地方容易與氧結合,在氧含量低的地方又容易與氧分離。血紅蛋白的這一特性,使紅細胞具有運輸氧氣的功能。
紅細胞的另一功能
紅細胞除可運送氧氣外,還可運送部分來自組織細胞中的二氧化碳。
免疫功能
增強吞噬作用
納爾遜(Nelson)用肺炎球菌和梅毒螺鏇體等進行體外實驗,發現被相應抗體致敏的肺炎球菌或梅毒螺鏇成熟紅細胞的代謝曲線
體,只有在含補體、紅細胞及白細胞的混合物中,80%~95%能迅速被吞噬而從液相中消失;若缺
 紅細胞
紅細胞少紅細胞,則在較長時間內僅有少數被吞噬。1956年Nelson又將抗體調理過的肺炎球菌注入猴
體內,獲得的結果與體外實驗相同,100%的肺炎球菌粘附於紅細胞。粘附的複合物較懸浮於血漿中游離的複合物更易被吞噬。某些病毒在體內也能粘附於紅細胞,從而被吞噬消滅。免疫粘附可以增強吞噬作用4~5倍。紅細胞還能阻止癌細胞在循環中播散,因在外周血中癌細胞遇到紅細胞比遇到白細胞的機會多500~1000倍。當癌細胞表面結合有抗體與補體時,則可通過紅細胞表面的C3b受體,使癌細胞粘附於紅細胞,故容易被吞噬細胞捕捉與吞噬,從而防止癌細胞的轉移與擴散。
另外,紅細胞還有吞噬細胞樣的功能,在其細胞膜表面具有過氧化物酶,該酶是典型的溶酶體酶,它可起著巨噬細胞樣的殺傷作用。
免疫粘附作用
免疫粘附是指抗原-抗體複合物與補體C3b結合後,可粘附於靈長目或非靈長目的紅細胞與血小板上,這紅細胞
一現象統稱為“血細胞免疫粘附作用”。紅細胞之所以具有免疫粘附作用,是因其表面具有C3b受體。該受體為糖蛋白,分子量為205000。紅細胞上的C3b受體占血循環中C3b受體總數的95%以上。因此,血循環中的抗原-抗體複合物遇到紅細胞比遇到白細胞的機會多500~1000倍。所以,紅細胞清除免疫複合物的特性是白細胞和淋巴細胞所不及的。
梅多福(Medof)等的體外實驗結果也支持上述推測。他們將抗原-抗體-補體複合物與人血細胞懸液混合併孵育,然後測定各類細胞結合免疫複合物的數量,結果發現紅細胞結合了82.8%~84.8%的複合物,而中性粒細胞和單核細胞分別只結合了8.3%~15.2%和1.6%~5.8%的複合物。
防禦感染
紅細胞與細菌、病毒等微生物免疫粘附後,不僅可以通過過氧化物酶對它們產生直接的殺傷作用,而且還可以促進吞噬細胞對它們的吞噬作用。因此,紅細胞的免疫功能可以看作是機體抗感染免疫的因素之一。
其他功能
目前已知紅細胞具有以下免疫功能:
1、識別攜帶抗原;
2、清除循環中免疫複合物;
3、增強T細胞依賴反應;
4、效應細胞樣作用;
5、促進吞噬作用。而這些免疫功能的生理學基礎即為紅細胞免疫粘附作用。
生成物質
概述
要生成紅細胞,需要一些重要的物質,其中包括了胺基酸、脂肪、碳水化合物、以及鐵(iron)和生長因子:葉酸(folicacid)與維生素B12(VitaminB12)。
鐵
鐵是使氧氣連結在血紅素上的重要元素。其來源於含鐵食物中(如肉類、蛋黃、肝臟、豆類、穀物、貝類等),不過當我們排出尿液、汗水、糞便,或是有表皮細胞的脫落時,都會造成少量鐵份的喪失,性成熟的女性更會因為月經而使鐵份流失。為了要保持鐵的平衡,必需食用含鐵的食物,例如肉類、肝臟、甲魚、蛋黃、豆類、堅果以及帶殼的五穀類。如果鐵原子不足,就會出現鐵缺乏(irondeficiency)的現象,血紅素的製造量會不足。降低氧氣運輸的效率。導致紅細胞形狀會變小,顏色較白,數目也會減少,臉色會呈現蒼白,舌頭會腫大、疼痛、手指甲易碎、出現隆起線條,都顯示缺鐵的徵兆。若鐵原子太多,則會引起嚴重的中毒。
當衰老的血紅素於脾臟和肝臟中分解後,它們的鐵離子會被釋放到血漿中並與鐵傳遞蛋白(transferrin)結合,大部分的鐵便是由此蛋白質被送回骨髓,以作為合成新紅細胞的原料。
鐵在人體中的代謝平衡主要由小腸上皮控制,它們會積極地從食物中吸收鐵質。在攝入的食物中,只有一小部份的鐵質被吸收,不過更重要的是,身體鐵平衡會影響鐵質的吸收,有時候吸收較多,有時候吸收較少。小腸上皮的鐵含量多少就決定了鐵原子吸收量:身體鐵原子越多,小腸上皮鐵原子含量就越高,於是吸收鐵原子的能力就越差。
肝臟會製造一種可以和鐵結合的蛋白,叫做鐵合蛋白(ferritin),這種蛋白質具有緩衝的作用,可以使缺鐵的情況沒有那么嚴重。身體內50%的鐵原子位在血紅素內,25%在鐵合蛋白(例如細胞色素),25%在肝臟的鐵合蛋白內。此外,鐵原子的再利用也是相當有效率:當老舊的紅細胞在脾臟以及肝臟內破壞之後,它們的鐵原子就會釋入血漿中,並和攜鐵蛋白(transferrin)結合。攜鐵蛋白具有傳送鐵原子的能力。幾乎所有經由攜鐵蛋白傳送的鐵原子都會送到骨髓內,當做製造紅細胞的原料。有一小部的鐵原子是來自細胞死亡後,細胞色素的鐵原子釋放出來,攜鐵蛋白也會攜帶這些鐵原子,送到骨髓內。
葉酸及維生素B12
葉酸屬於一種維生素,其在有葉植物、酵母菌、肝臟中的含量頗多,是構成胸腺嘧啶(thymine)的重要物質,對於DNA的合成相當重要,並進而影響了細胞的分裂,故當其含量不足時,便會影響細胞的正常分裂(尤其是像血紅素前質物等快速繁殖的細胞)。其中以增生迅速的細胞受到的影響最大(紅細胞前身細胞也是一種分裂迅速的細胞)。因此,如果葉酸缺乏的時候,紅細胞的製造量就會減少。
維他命B12為含鈷的維生素,所以又叫做cobalamin,雖然是合成的重要元素,但所需要的量相當少(一天只需1微克),對於葉酸的活動相當重要,葉酸必須靠維生素B12才能發揮其功能。維生素B12必須透過由胃分泌的造血內因子(intrinsicfactor),才可被人體吸收,內因子是一種由胃部分泌出來的蛋白質,如果缺乏這種蛋白質,就會引起維生素B12缺乏。而且維生素B12隻存在於動物性食物中,因此素食者會缺乏這種維生素。另外,由於其亦是髓鞘(myelin)合成的重要物質,所以當其缺乏時,往往會造成神經方面疾病及紅細胞不足的綜合病症。
生成介紹
人體每小時要製造5億新紅細胞。紅細胞主要在人體的骨髓(bonemarrow)內生成(特別是紅骨髓)。它靠紅細胞生成素(erythropoietin)與鐵離子產生。紅細胞生成素是一種荷爾蒙,一般稱為EPO,紅細胞的生成就是由它負責控制。它產生於腎臟的毛細血管上皮中(肝臟也有此功能,只是其分泌量相對少很多),然後再進入血液中,其會作用在骨髓上,促使紅細胞前質物的生成及分化,以增加紅細胞的數量。在正常情況下,紅細胞生成激素的數量並不需要太多就可以刺激骨髓製造紅細胞。當不斷監測血液的腎臟含氧量下降而以化學方式發出警告時,就會製造出較多量的紅細胞生成激素,使骨髓製造紅細胞的數量增加。紅細胞生成素便命令骨髓製造一批新的紅細胞。通過這樣的機制,攜氧量就會增加。
年輕未成熟的紅細胞——網纖紅質體(reticulocyte)中尚有一些線粒體,經由它們的分泌,網纖紅質體中會形成了一種網狀構造;如果利用特殊的染色,可以把這些網狀結構染出來,所以這些細胞就叫做網狀球(reticuocyte)。經過一連串的分化後,這些骨髓細胞就會開始製造血紅素,使紅細胞具備了血紅素,但它們的細胞核及線粒體等結構卻也會消失,分化成熟後,紅細胞便離開骨髓並進入循環系統,以執行其功能。在正常情況下,只有成熟的紅細胞(已經完全失去核糖體)才會離開骨髓,進入血液循環內。但是如果紅細胞不正常地大量製造,在血液中就能找到很多網狀球。
紅細胞生成素的分泌量於平常並不會太多,可是一旦輸送至腎臟的氧含量降低時(其情形有:
1.心臟的輸血量不足
2.肺臟發生疾病3.貧血4.處於較高海拔時),其分泌量便會大增,使氧氣運輸量在紅細胞增多後恢復正常。
當腎臟衰竭時,EPO無法正常合成,在血液透析過程中造成貧血,需要EPO來增加紅細胞的產生,在給予EPO的同時必須注意體內鐵離子的含量,如果體內鐵不足,注射EPO而不給予鐵離子是無法使紅細胞產生增加。
更新介紹
紅細胞不斷進行新生和破壞,根據同位素的實驗證明其壽命為100—120天,比要白血球長。所以紅十字會都會建議成年男子每隔三個月獻血一次,女子每隔四個月獻血一次。
由於紅細胞沒有細胞核以及細胞器,無法自行製造自己的結構,也無法使自己的結構維持長久。身體內每天紅細胞破壞量約1%,需加以補充。照這樣計算,人體每天要製造一百億個細胞。由於胎兒期造血而產生的紅細胞中,血紅素為胎兒血色素HgbF,適合於子宮內低氧狀態下的氣體交換,至成人期造血期,血色素便轉變為成人型血色素HgbA。
老化的紅細胞,主要在脾臟及肝臟的網狀內皮系統中破壞分解,血色素(heme)變為膽紅素(bilirubin),血球蛋白和鐵。血漿的顏色就是由膽色素所構成的,因此血色素變為膽紅素的這一過程使血漿變為淡黃色,被釋出的鐵離子大部分都會被保留起來,可利用於血色素的再合成,膽紅素與白蛋白結合,運往肝臟,經處理後,以膽汁的形式排出。同時血球蛋白可成為胺基酸,利用於蛋白質的再合成。人體每天有四五萬個紅細胞在脾臟及肝臟被破壞。
初生嬰兒由於新陳代謝率很快,紅細胞壽命則約有80天(兩個月),不過也由於其新陳代謝快,所以更快製造新的紅細胞來補充死去的紅細胞。
 紅細胞
紅細胞有些長期病患者如慢性腎衰竭的患者,其血液中紅細胞壽命可能會稍較正常的120天低一些,原因可能很多,一般而言主要因素應是這類病人體內堆積較多的代謝後毒性物質不易排除,而這些物質會傷害紅細胞,減短紅細胞的壽命。另外,某些腎衰竭患者的腎血管內皮組織可能有破損,紅細胞通過時,容易受到破壞,也可能是原因之一。
但是對於某些較低等的脊椎動物(比如青蛙),它們的紅細胞是有細胞核的,所以可以進行無絲分裂,通過縊裂的方式一分為二,產生新的紅細胞。
攜帶氧氣和二氧化碳
眾所周知,紅細胞是動物體內血細胞中數量最多,作用最強的細胞。它能夠攜帶氧氣和二氧化碳,使人體內部碳氧量保持平衡。但為什麼紅細胞具有這樣神奇的特性?原因皆來自於血紅蛋白。
血紅蛋白是一種含鐵的蛋白質,它具有一種神奇的特性:在含氧量高的地方與氧結合,在含氧量低的地方與氧分離。於是,當攜帶有二氧化碳的紅細胞隨著血液運輸到肺部毛細血管時,因為肺與外界進行氣體交換,所以含氧量高,血紅蛋白便於氧結合,而其中的二氧化碳隨著肺與外界進行氣體交換而排出體外。同理,流經組織細胞處毛細血管網時,含氧量低,血紅蛋白中的氧氣便進入到組織細胞之中,而組織細胞中的二氧化碳又進入血紅蛋白里。因此,紅細胞才能夠運輸氧氣和二氧化碳,成為血細胞中不可或缺的一份子!
細胞形態
紅細胞體積很小,直徑只有7~8μm,形如圓盤,中間下凹,邊緣較厚,呈圓餅狀。它具有彈性和可塑紅細胞
性,在通過直徑10μm的毛細血管時,須單獨通過,這樣有利與物質的交換。
正常成熟的紅細胞沒有細胞核,也沒有高爾基體和線粒體等細胞器,但它仍具有代謝功能。紅細胞內充滿著豐富的血紅蛋白,血紅蛋白約占細胞重量的32%,水占64%,其餘4%為脂肪、糖類和各種電解質。
其他形態
人的正常紅細胞的直徑為6-9微米,在此以上的為大紅細胞(macroc-yte),以下的為小紅細胞(microcyte),小紅細胞正常人偶見。大紅細胞多見於溶血性貧血及巨幼細胞貧血。
在15微米以上的為巨紅細胞(mega1ocyte),最常見於缺乏葉酸及維生素B12所致的巨幼細胞性貧血。
紅細胞大小不均(anisocytosis)是指在同一張血片上紅細胞之間直徑相差一倍以上而言。
另外紅細胞呈球形的稱為球形紅細胞(spherocyte),這種細胞直徑小於正常。厚度增加常大於2μm。無中心淺染色區,似球形。
呈橢圓形的稱為橢圓紅細胞(elliptocyte),細胞呈卵圓形、桿形、長度可大於寬度3-4倍,最大直徑可達12.5μm,橫徑可為2.5μm。
顯畸形的叫畸形紅細胞(poiki-locyte)。在畸形紅細胞里有有棘紅細胞(burrce-ll,acanthocyte)該紅細胞表面有針尖狀突起,其間距不規則。突起的長度和寬度右不一、口形紅細胞(stomatocyte)紅細胞中央有裂縫,中心蒼白區呈扁平狀,頗似張開的口形或魚口。以及星狀紅細胞(starcell,astro-cyte)等。
紅細胞的斷片為分裂紅細胞(schistocy-te)、紅細胞碎片或不完整的紅細胞。大小不一。外形不規則,有各種形態如刺形、盔形、三角形、扭轉形等。
地中海貧血所多見的於紅細胞中央呈濃染的稱為靶紅細胞(targetcell,leptocyte),靶紅細胞中心部位染色較深,其外圍為蒼白區域,而細胞邊緣又深染,形如射擊之靶。
中央部淡染的稱為平皿形紅細胞(anulocyte)。也有起源於HgbS的鐮狀紅細胞(sicklecell,drepanocyte)形如鐮刀狀。
另外在紅細胞內,有可呈柏林藍反應的鐵顆粒的稱為鐵紅細胞(siderocyte),也有發出卟啉原螢光的螢光紅細胞(fluorocyte)。呈現半月狀的淡染脫色紅細胞(achromacyte),脫色網狀紅細胞(achromo-reticulocyte)是人為
地從紅細胞溶出血色素的細胞。
紅細胞形態不整(poikilocytosis)指紅細胞形態發生各種明顯改變的情況而言,可呈淚滴狀、梨形、棍棒形、新月形等。
正常色素性(normochmic)是指正常紅細胞在瑞特染色的血片中為淡紅色圓盤狀,中央有生理性空白區,通常呈
正常色素性。
低色素性(hypochromic)是紅細胞的生理性中心淺染色區擴大,甚至成為環圈形紅細胞,提示其血紅蛋白含量明顯減少。
在惡性貧血等所見到的紅細胞是高血色素性(hyperchromic)的,指紅細胞內生下性中心淺染區消失,整個紅細胞均染成紅色,而且胞體也很大。
嗜多色性(polychromatic)多見於尚未完全成熟的紅細胞,故細胞較大,由於胞質中含人多少不等的嗜鹼性物質RNA而被染成灰色、藍色。
鹼性點彩紅細胞(basophilicstipplingcell)簡稱點彩紅細胞,指在瑞吉氏染色條件下,胞質記憶體在嗜鹼性灰藍色顆粒的紅細胞,屬於未完全成熟紅細胞,其粒顆大小不一、多少不等、正常人血塗片中很少見到,僅為萬分之一。
染色質小體(howelljollysbody)位於成熟或幼紅細胞的胞質中,呈圓形,有1-2μm大小,染紫紅色,可1至數個。
卡波環(cabotring)在嗜多色性或鹼性點彩紅細胞的胞質中出現的紫紅色細線圈狀結構,有時繞成8字形。
有核紅細胞(nucleatederyhrocyte)即幼稚紅細胞,存在於骨髓中。正常成人外周血液中不能見到。
紅細胞數
男性
380萬-600萬個/mm3;正常指標:4.0-5.5X10的12次方個/每升。
女性
380萬-550萬個/mm3;正常指標:3.5-5.0X10的12次方個/每升。
血液中大部分成分為紅細胞,紅細胞會將肺部的氧氣運送到全身的組織細胞,並將二氧化碳帶出。
其他
紅細胞數量減少時,氧氣的搬運能力會降低,變成缺氧狀態,產生貧血;嚴重時會有生命危險。但如果增加過多,血液會變濃,不易流動,血管容易阻塞。
紅細胞非常小,在1立方毫米的血液里含有500萬個紅細胞,人體內的紅細胞數可達250億個。
紅細胞數目可隨外界條件和年齡的不同而有所改變。高原居民和新生兒可達600萬/mm3以上。從事體育運動或經常鍛鍊的人紅細胞數量也較多。血紅蛋白含量,男性為12~15g/100ml,女性為11~13g/100ml。
生理特性
滲透脆性
正常狀態下紅細胞內的滲透壓與血漿滲透壓大致相等,這對保持紅細胞的形態甚為重要。將機體紅細胞置於等滲溶液(哺乳動物:0.9%NaCl)中,它能保持正常的大小和形態。但如把紅細胞置於高滲NaCl溶液中,水分將逸出胞外,紅細胞將因失水而皺縮。相反,若將紅細胞置於低滲NaCl溶液中,水分進入細胞,紅細胞膨脹變成球形,可至膨脹而破裂,血紅蛋白釋放入溶液中,稱為溶血。
把正常人紅細胞置入不同濃度的溶液中(從0.85%、0.8%……0.3%NaCl溶液),在0.45%的溶液中,有部分紅細胞開始破裂,即上層液體呈微紅色,當紅細胞在0.35%或更低的NaCl溶液中,則全部紅細胞都破裂。臨床以0.45%NaCl到0.3%NaCl溶液為正常人體紅細胞的脆性(也稱抵抗力)範圍。如果紅細胞放在高於0.45%/NaCl溶液中時即出現破裂,表明紅細胞的脆性大,抵抗力小;相反,放在低於0.45%NaCl溶液中時才出現破裂,表明脆性小,抵抗力大。
懸浮穩定性
懸浮穩定性是指紅細胞在血漿中保持懸浮狀態而不易下沉的特性。將與抗凝劑混勻的血液置於血沉管中,垂直靜置,經一定時間後,紅細胞由於比重大,將逐漸下沉,在單位時間內紅細胞沉降的距離,稱為紅細胞沉降率(簡稱血沉)。以血沉的快慢作為紅細胞懸浮穩定性的大小。正常男子第1小時末,血沉不超過3mm,女子不超過10mm。在妊娠期,活動性結核病,風濕熱以及患惡性腫瘤時,血沉加快。臨床上檢查血沉,對疾病的診斷及預後有一定的幫助。
關於維持紅細胞懸浮穩定性的原因,有人認為是由於紅細胞表面帶有負電荷之故,因為同性電荷相斥,紅細胞不易聚集,從而呈現出較好的懸浮穩定性。如果血漿中帶正電荷的蛋白質增加,其被紅細胞吸附後,使之表面電荷量減少,這樣就會促進紅細胞的聚集和疊連,使總的外表面積與容積之比減少,摩擦力減小,血沉加快。血沉的快慢主要與血漿蛋白的種類及含量有關。
紅細胞內的血紅蛋白能與O2結合成HbO2,將O2由肺運送到組織,血中的O2有98.5%是以HbO2形勢被運輸的。血紅蛋白還能與CO2結合成HbNHCOOH,將CO2由組織運送到肺。另外,紅細胞內含有豐富的碳酸酐酶,在碳酸酐酶作用下使CO2約占血液運輸CO2總量的88%。可見,紅細胞在O2和CO2運輸過程中起重要的作用。
吸水性
紅細胞沒有細胞壁,內部溶液濃度高,由於滲透壓大量吸水,會漲破細胞膜,內容物流出。
易變形
由於紅細胞無細胞核,有細胞膜和細胞質(主要是血紅蛋白)構成,細胞質中的血紅蛋白是晶體,且為液晶,因此紅細胞的變形主要取決於細胞膜的力學性質。紅細胞的尺寸約5-8um,毛細血管的直徑只有2-3um,但紅細胞能夠通過毛細血管,就是因為紅細胞易變形。
關於其他
成熟的紅細胞沒有細胞核,呈兩面中間凹的圓餅狀,平均直徑為7微米。正常成年男子紅細胞個數約為5*10^12個/L,女子約為4.2*10^12個/L。紅細胞壽命一般為120天。骨骼中的紅骨髓可以產生新的紅細胞補充衰老或被破壞的紅細胞。
血液中的紅細胞過少,或者血紅蛋白數量過少,叫做貧血。正常成人血紅蛋白量男性為12~16克/100毫升,女性為11~15克/100毫升;紅細胞數男性為400~550萬/立方毫米,女性為350~500萬/立方毫米。凡低於以上指標的即是貧血。一般的貧血患者應多吃一些蛋白質和鐵豐富的食物。
病症介紹
紅細胞增多症(Polycythemia)以紅細胞數目、血紅蛋白、紅細胞壓積和血液總容量顯著地超過正常水平為特點。兒童時期血紅蛋白超過180g/L(16g/dl),紅細胞壓積大於55%和每公斤體重紅細胞容量絕對值超過35ml,排除因急性脫水或燒傷等所致的血液濃縮而發生的相對性紅細胞增多,即可診斷。
本症可分為原發性與繼發性兩大類。原發性的即真性紅細胞增多症;繼發性的主要是由組織缺氧所引起的。
醫學檢查
前言
血紅細胞的兩大醫學檢查:血常規紅細胞、尿常規紅細胞。血常規檢驗的是血液的細胞部分。
血常規紅細胞
血液有三種不同功能的細胞——紅細胞,白細胞、血小板。通過觀察數量變化及形態分布,判斷疾病。是醫生診斷病情的常用輔助檢查手段之一。
[正常參考值]
男:4.0~5.5×10^12/L(400萬-550萬個/mm3)。
女:3.5~5.0×10^12/L(350萬-500萬個/mm3)。
新生兒:6.0~7.0×10^12/L(600萬-700萬個/mm3)。
[臨床意義]
紅細胞減少①紅細胞生成減少,見於白血病等病:②破壞增多:急性大出血、嚴重的組織損傷及血細胞的破壞等③合成障礙:缺鐵,維生素B12的缺乏等
紅細胞增多常見於身體缺氧、血液濃縮、真性紅細胞增多症、肺氣腫等。
尿常規紅細胞
尿常規紅細胞是指做尿常規檢查中三種細胞中的血紅細胞。正常尿液中,一般無細細胞或僅有個別紅細胞。離心後的尿液,如顯微鏡每一高倍視野平均可見1~2個紅細胞,即為異常表現;如每個高倍視野紅細胞在3個以上,而尿外觀無血色者,稱為鏡下血尿;如尿外觀呈洗肉水樣或赭紅色,則為肉眼血尿。血尿常見於急性腎炎、慢性腎炎、腎結核、腎腫瘤等。
若尿中出現多量紅細胞,則可能由於腎臟出血、尿路出血、腎充血等原因所致。劇烈運動及血液循環障礙等,也可導致腎小球通透性增加,而在尿中出現蛋白質和紅細胞。
同名電影
影片類型:
驚悚/恐怖
片長:
USA:87min
國家/地區:
美國
對白語言:
英語
色彩:
彩色
幅面:
35毫米無聲標準銀幕
演員表
角色演員配音備註
Mrs.FenwayJanetGreen--------
GhostChrisSchwartz--------
AydenFenwayDonovanSchwartz--------
DoctorBobStrouse--------
Dr.ZeamanBrettWilson--------
職員表
?出品人:
?製作人:ChrisSchwartz
?原著:
?導演:ChrisSchwartz
?副導演(助理):
?編劇:ChrisSchwartz
?攝影:
?配樂:StevenHero
?剪輯:ChrisSchwartz
?道具:
?選角導演:
?配音導演:
?藝術指導:
?美術設計:
?動作指導:
?造型設計:
?服裝設計:
?視覺特效:
?燈光:
?錄音:
?劇務:
?場記:
?布景師:
?發行:
?監製:

